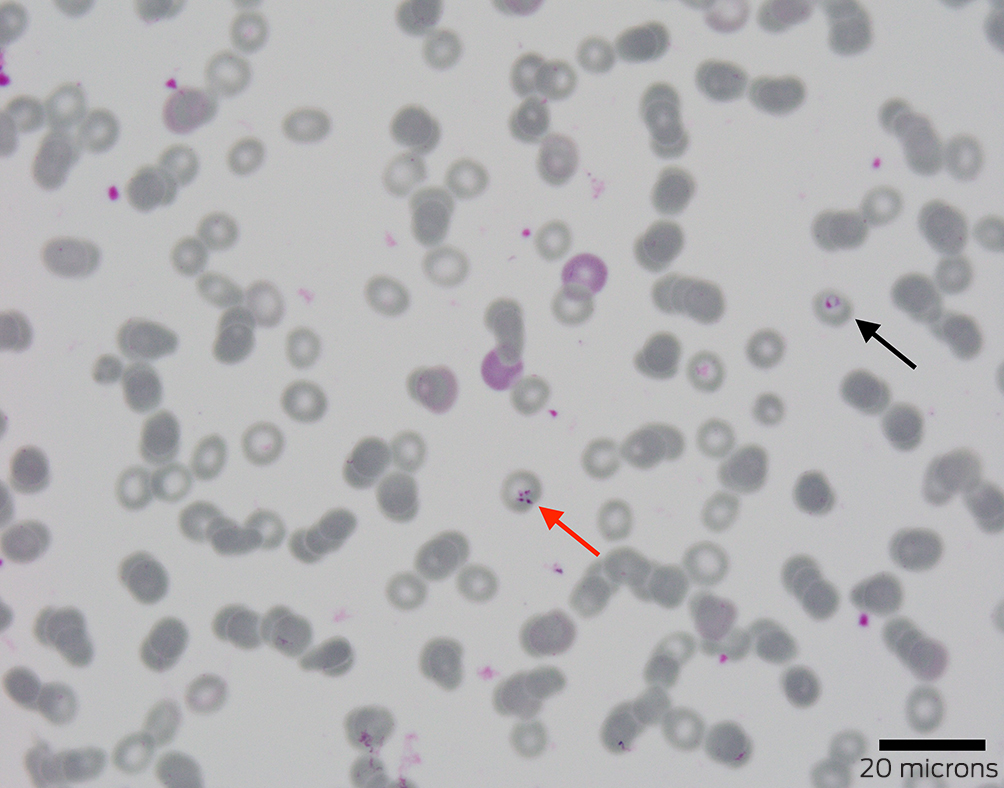

Clinical record
A 62‐year‐old man from Connecticut, USA, presented to the emergency department with a six‐day history of a febrile illness featuring headache, fatigue, malaise and anorexia. Medical history was limited to dyslipidaemia and hypertension and he was not known to be immunocompromised.
His fevers began a day after returning from a safari in West Arnhem Land (Box 1). The safari involved boating in billabongs and hiking through bush and flood plains. His travel history included birding expeditions to Central America, with the latest six months prior. He regularly hiked in Connecticut forests and had been camping recently in Maine. Before the safari, he spent two days in Darwin and recalled a stinging in his groin while touring a gallery. The next morning, he removed a suspected tick from his scrotum while showering.
On presentation, he was febrile at 39°C. The only examination finding of note was a 2 × 2 mm midline scrotal punctum without eschar or surrounding cellulitis. Routine pathology showed pancytopenia with evidence of inflammation and intravascular haemolysis (Box 2), and a computed tomography scan showed splenomegaly with two small splenic infarcts.
Ceftriaxone and doxycycline were given for broad antimicrobial coverage, including leptospirosis and rickettsiosis. Blood film examination investigating the haemolysis detected an intracellular parasitosis affecting 1.6% of erythrocytes. Although morphology was not characteristic of Plasmodium species, empirical intravenous (IV) artesunate was added. Malarial antigen screening, a mosquito‐borne polymerase chain reaction (PCR) panel, and leptospirosis and rickettsiosis testing returned negative results.
Further review of the blood film identified merozoites in a Maltese cross tetrad (Box 3), consistent with Babesia species. Therapy was rationalised to ten days of oral atovaquone, azithromycin and doxycycline — the latter covering possible co‐infection. Reference laboratory PCR results and whole genome sequencing definitively confirmed Babesia microti about two months after presentation.
Discussion
The differential diagnosis for this patient's presenting illness was expanded by his birding trips in Costa Rica, Mexico, Panama and Belize. Typical infection incubation periods helped to narrow the suspects (with the exception of relapsing malaria). A six‐month incubation period excludes arboviral infections such as Zika, Chikungunya, yellow fever, West Nile virus, and the equine encephalitides.1 Melioidosis is almost always a consideration in the Top End of the Northern Territory and is recognised as a potentially fatal infection periodically recorded in travel medicine literature.1 However, the patient didn't have the traditional risk factors and exposures heralding disseminated disease, and his travel occurred in the dry season when incidence is lowest. Leptospirosis was considered but compatible animal and water exposures were missing. The absence of neurological symptoms rendered Murray Valley encephalitis and Japanese encephalitis, both present in Darwin and its surrounds, less likely. A generalised vasculitis of a rickettsial infection (particularly scrub typhus caused by Orientia tsutsugamushi) was a leading differential, although the imaging and laboratory results — namely the pancytopenia — would be rare manifestations.2
Investigations initially focused on the Top End's tropical milieu, prompting targeted serological and nucleic acid amplification testing. The true culprit, however, was almost certainly imported from New England's temperate climes aboard a hitchhiking tick.
Babesia are intracellular protozoan parasites that, in the United States, are primarily transmitted via Ixodes scapularis, the deer or black‐legged tick.3 Maine and Connecticut are in the Centre for Disease Control's (CDC) top four states for annual babesiosis incidence.4 Infections are highest in North American late spring and early summer (coinciding with the patient's Maine camping trip).5 Symptoms usually resemble an influenza‐like syndrome. Splenic infarcts and rupture are rare but can occur secondary to otherwise mild disease.5
Diagnosing acute babesiosis preferentially relies on identifying Babesia parasites on a peripheral blood smear or via PCR testing.6 Merozoite tetrads in a Maltese cross arrangement are considered pathognomonic and meet the CDC's case definition.3 American guidelines recommend a seven to ten day course of atovaquone and azithromycin for symptomatic immunocompetent patients.6 Distinguishing babesiosis from other tick‐related infections, such as human granulocytic anaplasmosis, Lyme disease and ehrlichiosis, often relies on PCR and serological tests, which are not readily available in Australia. The possibility of co‐infection with another tick‐borne disease — present in as many as 40% of patients — may require empirical treatment.6,7
Babesiosis can clinically and microscopically mimic malaria.8 The catastrophic consequences of missing severe malaria, and the relative safety of artesunate, mean that uncertainty regarding the identity of intra‐erythrocyte parasites in an unwell patient with a compatible travel history should be treated as severe malaria until proven otherwise. Prompt IV artesunate can be lifesaving; administration must be confirmed by prescribers as staff unaware of its urgency may delay locating supplies until business hours — when it could already be too late.
Lessons from practice
- Fever in the arriving traveller can present as much a diagnostic challenge as fever in the returned traveller and requires similar application of an epidemiological and exposure lens relevant to the place of origin.
- Babesiosis is a tick‐borne protozoal infection that presents as a non‐specific febrile illness, with diagnosis largely hinging on the presence of intra‐erythrocytic parasites seen on blood film examination.
- As co‐infection is not uncommon and more specific diagnostics are not readily available, babesiosis treatment typically consists of atovaquone and azithromycin with empirical doxycycline for additional cover if other tick‐borne diseases have yet to be definitively excluded.
- Malaria should always be considered in the differential diagnosis for patients with a febrile illness and a compatible travel history and, given the potentially catastrophic consequences of missing severe malaria, empirical intravenous artesunate may be warranted.
Box 1 – Timeline

IV = intravenous; GP = general practitioner; PCR = polymerase chain reaction; US = United States.
Box 2 – Pathology results on presentation to the emergency department
|
Laboratory finding |
On presentation (reference interval) |
||||||||||||||
|
|
|||||||||||||||
|
Haemoglobin, g/L |
97 (135–185) |
||||||||||||||
|
White cell count, × 109/L |
2.1 (4.0–11.0) |
||||||||||||||
|
Absolute neutrophil count, × 109/L |
1.3 (2.0–7.5) |
||||||||||||||
|
Absolute lymphocyte count, × 109/L |
0.5 (1.5–4.0) |
||||||||||||||
|
Platelet count, × 109/L |
64 (150–450) |
||||||||||||||
|
C‐reactive protein, mg/L |
261.2 (< 5.0) |
||||||||||||||
|
Total bilirubin, μmol/L |
33 (< 21) |
||||||||||||||
|
Direct bilirubin, μmol/L |
17 (0–7) |
||||||||||||||
|
Reticulocyte count, × 109/L |
88.2 (20–100) |
||||||||||||||
|
Lactate dehydrogenase, U/L |
1321 (120–250) |
||||||||||||||
|
Haptoglobin, g/L |
< 0.06 (0.36–1.95) |
||||||||||||||
|
|
|||||||||||||||
|
|
|||||||||||||||
Provenance: Not commissioned; externally peer reviewed.
- 1. Thwaites GE, Day NPJ. Approach to fever in the returning traveler. N Eng J Med 2017; 376: 548‐460.
- 2. Kim DM, Kim SW, Choi SH, Na RY. Clinical and laboratory findings associated with severe scrub typhus. BMC Infect Dis 2010; 10: 108.
- 3. Westblade LF, Simon MS, Mathison BA, Kirkman LA. Babesia microti: from mice to ticks to an increasing number of highly susceptible humans. J Clin Microbiol 2017; 55: 2903‐2912.
- 4. Swanson M, Pickrel A, Williamson J, Montgomery S. Trends in reported babesiosis cases ‐ United States, 2011‐2019. MMWR Morb Mortal Wkly Rep 2023; 72: 273‐277.
- 5. Waked R, Krause PJ. Human babesiosis. Infect Dis Clin North Am 2022; 36: 655‐670.
- 6. Krause PJ, Auwaerter PG, Bannuru RR, et al. Clinical practice guidelines by the Infectious Diseases Society of America (IDSA): 2020 guideline on diagnosis and management of babesiosis. Clin Infect Dis 2021; 72: e49‐e64.
- 7. Ssentongo P, Venugopal N, Zhang Y, et al. Beyond human babesiosis: prevalence and association of Babesia coinfection with mortality in the United States, 2015‐2022. Open Forum Infect Dis 2024; 11: ofae504.
- 8. Homer MJ, Aguilar‐Delfin I, Telford SR, et al. Babesiosis. Clin Microbiol Rev 2000; 13: 451‐469.

Patient consent:
The patient provided written consent for publication.
No relevant disclosures.